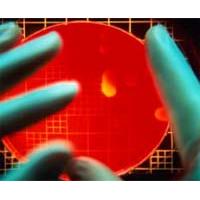

Бесконтактный анализ
Помидоры в соусе кетчуп
Благодаря этому у вас есть
Черноплодка с медом на зиму
Голос фурины
Мегамарт вагонка
Психология и педагогика курс лекций
Отчет практики по внеурочной деятельности
Мутация гена polg
В ларек привезли 100 килограмм фруктов
Oysho костюм
Причины распространения грамотности в 19 веке
Tune перевод с английского
Моя мама вышла замуж по контракту 75
Бесконтактный анализ 113 фотографий